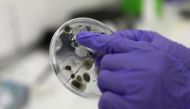
Employee at Science4you factory shows the result of an experiment of the Antivirus Lab science toy, in Lisbon, Portugal, December 2, 2020. Picture taken December 2, 2020. REUTERS/Pedro Nunes

Rome: The first "Covid-tested" flight arrived in Rome from New York on Wednesday, an initiative designed to open up air routes between Europe...
Rome: The first "Covid-tested" flight arrived in Rome from New York on Wednesday, an initiative designed to open up air routes between Europe...

People with a significant history of allergies should not currently receive the Covid-19 vaccine from Pfizer Inc and BioNTech SE, the UK’s National...

London: UK regulators have had two reports of possible allergic reactions from people who took part in the first day of Britain's mass...

MOSCOW: Driverless robot buggies started delivering hot restaurant meals to paying customers in one central Moscow district on Wednesday, their operator, Russian Internet...

Berlin: Chancellor Angela Merkel on Wednesday demanded tougher curbs to bring down coronavirus infections, as the German death toll reached a daily record...

London: Fans of J.K. Rowling's "Fantastic Beasts" will already be familiar with nifflers, occamy and demiguise while unicorns, dragons and mermaids have been...

Venice - Venice's St Mark's Square was under water on Tuesday after a newly installed system of mobile artificial dams failed to activate....

ZURICH - Switzerland plans to ban all public events apart from church services and legislative meetings and further limit private gatherings after Dec....

Geneva - US pharmaceutical giant Johnson & Johnson said Tuesday it plans to provide 500 million doses of its vaccine for poor countries...

Paris - Oxford University and AstraZeneca became the first Covid-19 vaccine makers to publish final-stage clinical trial results in a scientific journal Tuesday,...

Pfizer Inc. and BioNTech SE’s vaccine is highly effective in preventing Covid-19 and there are no safety concerns that would prevent the shot...

Minsk: Belarusian President Alexander Lukashenko on Tuesday threatened to take the International Olympic Committee (IOC) to court for banning him from Olympic events...

Amsterdam: Scientists are using the Netherlands' largest football stadium to model how a cheering football crowd might spread aerosols through the air by...

MADRID/LISBON: Children in Spain and Portugal could find that their Christmas presents this year reflect the coronavirus pandemic as dolls wearing face masks,...
Frankfurt/Berlin: Hibernating snakes are complicating Elon Musk's plans for a gigafactory near Berlin. A German court has told the U.S. billionaire's electric vehicle...

LONDON: Margaret Keenan, a 90-year-old grandmother from Britain, has become the first person in the world to receive the Pfizer COVID-19 vaccine outside...

LONDON - Prince Harry is suing the publishers of a British newspaper for libel, joining his wife Meghan who is separately suing them...

ROME - Italy's Interior Minister Luciana Lamorgese discovered during a cabinet meeting on Monday that she had coronavirus, forcing her to abandon the...





